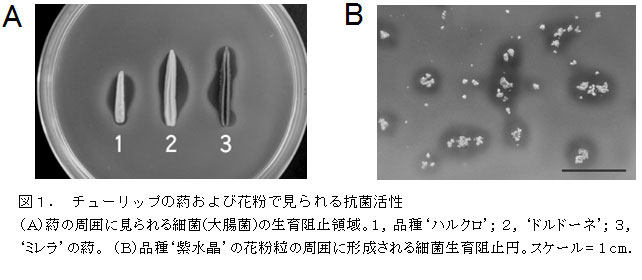

チューリップの葯における抗菌性物質Tuliposide Bの蓄積 |
|
| [要約] |
チューリップの葯は、開花直前に抗菌性物質Tuliposide Bを組織特異的に生合成し、花粉を細菌類の侵入から守る独自の防御機構を発達させている。 |
![]()
[キーワード]チューリップ、抗菌性物質、感染防御、葯、花粉、チューリッポシド |
![]()
[担当]富山農技セ・農試・生物工学課
[代表連絡先]電話:076-429-2113
[区分]関東東海北陸農業・花き、生物工学
[分類]研究・参考 |
|
| [背景・ねらい] |
富山県におけるチューリップ球根の生産では、球根肥大化のため花は開花直後に摘み取られる。この花を有効活用するため、花の中に含まれる機能性物質の探索を進めている過程で、チューリップの葯に強い抗菌活性を見出した。そこで、その原因物質の解明と生理的役割を明らかにする。 |
![]()
[成果の内容・特徴] |
| 1. |
チューリップの葯や花粉には、抗菌活性物質が存在する(図1)。 |
| 2. |
葯を水で抽出し、液体クロマトグラフィーによる精製とNMRによる構造解析を行った結果、活性物質はTuliposide Bである(図2A) |
| 3. |
葯以外の組織では、Tuliposide AとTuliposide Bの両方が存在する。特に、葯ではTuliposide Bだけが特異的かつ高濃度に存在する(図2B)。 |
| 4. |
Tuliposide Bは、細菌類に広く抗菌活性を示すが、酵母類のカンディダ菌には効果を示さない(表1)。 |
| 5. |
葯でのTuliposide Bの生合成は、開花14日前から始まり7日前に最大に達する時期特異性を示す(図3)。 |
|
![]()
[成果の活用面・留意点] |
| 1. |
Tuliposide Aはアレルゲン性をもつが、Tuliposide Bのアレルゲン性は低いことが報告されている。 |
| 2. |
摘花をバイオマスとした抗菌液の作製とその活用が期待されることから、異分野での活用に取り組んでいる。 |
| 3. |
Tuliposide AおよびBのチューリップ病原菌に対する抗菌活性を調査中である。いくつかの病原菌に対する殺菌効果や含有量に品種間差異が認められることから、Tuliposideの含有量を指標にした新たな耐病性評価法の開発に取り組んでいる。 |
|
|
[具体的データ]
|
|
|
|
![]()
[その他] |
研究課題名:チューリップ摘花の機能性物質とその利用開発
予算区分:他委
研究期間:2003~2006年度
研究担当者:荘司和明、桃井千巳、辻 俊明、生方 信(北大院・農)
発表論文等:
・Shoji et al., (2005) J. Japan. Soc. Hort. Sci. 74: 469-475.
・特許:特願2003-92895.
|
|
| 目次へ戻る |